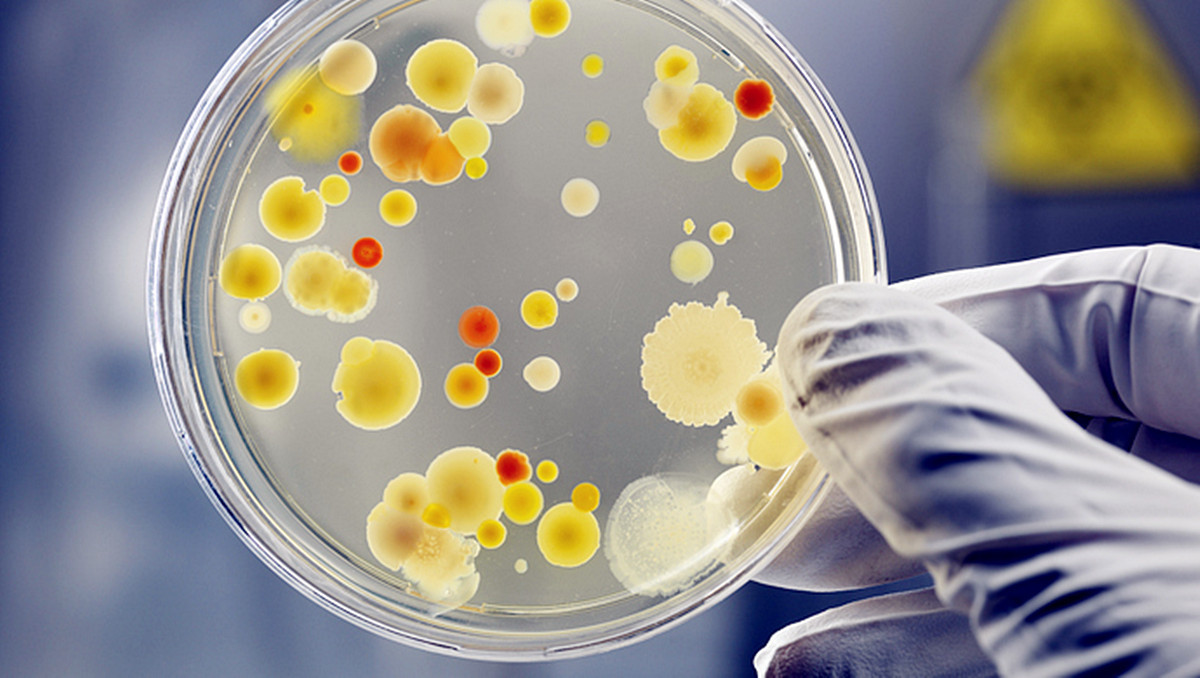
炎症期间可以用湿巾擦屁屁吗,湿厕纸擦屁股有必要吗

擦屁屁的时候你是用干纸还是湿厕纸呢?[思考]
有的人感觉,菊部地区皮肤皱褶比较多,用湿厕纸更容易擦干净,拉完粑粑后,用湿厕纸擦的感受也会更好。
而有的人用完湿厕纸之后,菊部地区则出现瘙痒、发红等症状,甚至还引发了妇科炎症。

为什么用湿厕纸会引发妇科炎症呢?
1. 潮湿环境,滋生细菌
有些湿厕纸甚至能拧出水来,那用它擦完屁屁,会让屁屁处于潮湿的状态,而且还有可能打湿*裤内**,如果不巧你又穿了紧绷的裤子,那你的*处私**就会处在潮湿闷热的环境,这种环境可是细菌微生物最喜欢的了,这就增加了阴道炎的发生风险。
2. 过度摩擦,屏障受损
用湿厕纸的人都是希望能够擦的干净一点,而有些“强迫症”就会想要面面俱到,再多擦擦,这就会导致接触性皮炎,这就是出现瘙痒、有灼烧感的原因。

3. 成分刺激,皮肤敏感
由于生理结构的问题,环境封闭、潮湿、容易摩擦的皮肤就会更敏感,更容易受到刺激。而有些湿厕纸为了达到“抑菌除菌”的效果,会使用些消毒剂、香精等物质,反而会增加私密处的敏感性。
一定要选择符合国家标准的哦~
